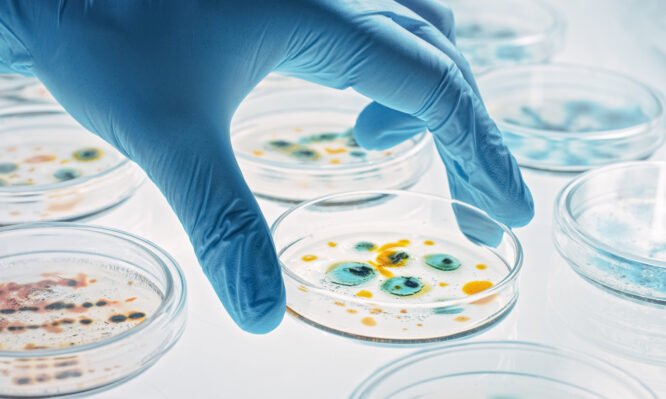
αντιβιοτικά

Αντιβιοτικά: Νέα μέθοδος αποκαλύπτει ποια φάρμακα σκοτώνουν πραγματικά τα βακτήρια
Πολλά αντιβιοτικά που χρησιμοποιούνται σήμερα λειτουργούν απλώς ως «φρένο», εμποδίζοντας τον πολλαπλασιασμό των βακτηρίων, χωρίς απαραίτητα να τα εξοντώνουν. Αυτό το κενό επιτρέπει σε λοιμώξεις να επανεμφανίζονται, συχνά πιο ανθεκτικές από πριν.
Μια ερευνητική ομάδα από το Πανεπιστήμιο της Βασιλείας στην Ελβετία υπόσχεται τώρα να αλλάξει τα δεδομένα, αναπτύσσοντας μια μέθοδο που παρακολουθεί την τύχη κάθε βακτηρίου ξεχωριστά.
Aντιβιοτικά – Η πρόκληση της βακτηριακής «αδράνειας»
Το μεγαλύτερο εμπόδιο για την οριστική εξάλειψή τους, δεν είναι πάντα η γενετική ανθεκτικότητα των μικροβίων, αλλά η ικανότητά τους να περιέρχονται σε μια κατάσταση ιδιότυπου λήθαργου. Σε αυτή τη φάση, τα βακτήρια παύουν να πολλαπλασιάζονται.
«Παγώνουν» κάθε ζωτική τους δραστηριότητα, γεγονός που τα καθιστά ουσιαστικά αόρατα για τα συμβατικά αντιβιοτικά, τα οποία είναι σχεδιασμένα να επιτίθενται σε κύτταρα που αναπτύσσονται ενεργά.
Αυτή η στρατηγική επιβίωσης επιτρέπει στα βακτήρια να παραμένουν αθόρυβα στον οργανισμό και να επανενεργοποιούνται αμέσως μόλις ολοκληρωθεί ο κύκλος της θεραπείας, προκαλώντας νέες λοιμώξεις. Είναι ο κύριος λόγος που ασθένειες όπως η φυματίωση απαιτούν εξαντλητικές θεραπείες πολλών μηνών.
Σύμφωνα με τα αποτελέσματα της μελέτης που δημοσιεύθηκαν στο έγκριτο επιστημονικό περιοδικό Nature Microbiology, η κατανόηση αυτού του μηχανισμού είναι το «κλειδί» για να σταματήσουμε να στοχεύουμε στα τυφλά και να αναπτύξουμε φάρμακα που εξοντώνουν πραγματικά το παθογόνο, ανεξάρτητα από το αν βρίσκεται σε φάση ανάπτυξης ή ληθάργου.
Το μικροσκόπιο ως όπλο: Η «ακτινογραφία» της βακτηριακής μάχης
Απέναντι σε αυτή την ικανότητα των βακτηρίων να «κρύβονται» στην αδράνεια, οι παραδοσιακές εργαστηριακές δοκιμές αποδεικνύονται συχνά ανεπαρκείς.
Μέχρι σήμερα, η αξιολόγηση των φαρμάκων γινόταν σε ομαδικά δείγματα, προσφέροντας μια γενική και ενίοτε παραπλανητική εικόνα που δεν μπορούσε να εντοπίσει τους μεμονωμένους επιζώντες.
Η νέα προσέγγιση, ωστόσο, που ονομάζεται «δοκιμή αντιμικροβιακής δράσης σε μονοκύτταρα» (single-cell testing), έρχεται να αλλάξει ριζικά την κλίμακα της παρατήρησης.
Αντί για μια συνολική εκτίμηση, οι ερευνητές χρησιμοποιούν πλέον προηγμένη μικροσκοπία για να θέσουν υπό στενή επιτήρηση εκατομμύρια μεμονωμένα βακτήρια επί σειρά ημερών.
Αυτή η συνεχής παρακολούθηση σε πραγματικό χρόνο επιτρέπει στην επιστημονική ομάδα να καταγράφει με απόλυτη ακρίβεια όχι μόνο ποια φάρμακα αναστέλλουν την ανάπτυξη, αλλά ποια καταφέρνουν όντως να εξοντώσουν το παθογόνο και σε πόσο χρόνο.
Η δυναμική αυτής της μεθόδου δοκιμάστηκε ήδη στην πράξη από την ομάδα του επικεφαλής της έρευνας, Δρ. Λούκας Μπεκ, η οποία ανέλυσε 65 διαφορετικούς συνδυασμούς φαρμάκων κατά του βακίλου της φυματίωσης.
Παράλληλα, η έρευνα επεκτάθηκε σε δείγματα από 400 ασθενείς που έπασχαν από σοβαρές πνευμονικές λοιμώξεις, αποδεικνύοντας ότι η θεραπεία μπορεί να προσαρμοστεί στις ιδιαιτερότητες κάθε περίπτωσης.
Όπως χαρακτηριστικά αναφέρει ο Δρ. Μπεκ:
«Η τεχνολογία αυτή μας επιτρέπει να δούμε τη μάχη σε επίπεδο μονάδας. Μπορούμε πλέον να γνωρίζουμε με βεβαιότητα ποιο φάρμακο είναι ικανό να καθαρίσει πλήρως τον πληθυσμό των βακτηρίων, εξαλείφοντας κάθε εστία κινδύνου».
Το μέλλον της θεραπείας
Τα ευρήματα της μελέτης ανοίγουν τον δρόμο για τη ιατρική παρέμβαση ακριβείας στις λοιμώξεις. Στο άμεσο μέλλον, η μέθοδος αυτή θα επιτρέπει στους γιατρούς:
- Να επιλέγουν το ιδανικό «κοκτέιλ» αντιβιοτικών για το συγκεκριμένο στέλεχος που φέρει ο κάθε ασθενής.
- Να προβλέπουν την επιτυχία μιας θεραπείας πριν καν αυτή ξεκινήσει.
- Να επιταχύνουν την ανάπτυξη νέων φαρμάκων, κατανοώντας τις στρατηγικές επιβίωσης των παθογόνων.
Φωτογραφία istock







